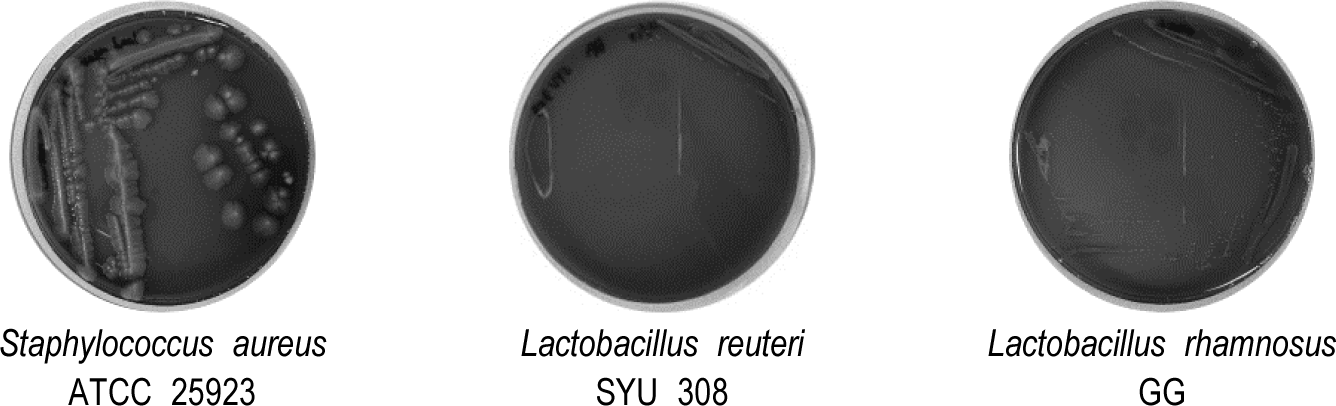

서 론
프로바이오틱스(probiotics)는 적정량 섭취 시 숙주의 건강에 유익한 효과를 제공하는 살아있는 미생물로 정의되며 최근에는 이들의 다양한 생리활성 기능이 보고됨에 따라 건강기능식품, 동물 사료첨가제, 의약품 등 다양한 산업 분야에서 활발히 활용되고 있다[1,2]. 프로바이오틱스가 체내에서 효과적으로 기능성을 발휘하기 위해서는 소화기관 내 위산 및 담즙산 등과 같은 환경에서 생존한 뒤 장까지 도달할 수 있어야 하며 장내 상피세포에 부착하여 일정 시간 이상 정착하는 능력이 요구된다[3,4]. 따라서 내산성 및 내담즙성과 장 상피세포에 대한 부착능은 프로바이오틱스로 활용하기 위한 균주를 선발할 때 고려해야 할 중요한 지표로 간주된다[5].
Lactobacillus reuteri 균주는 다양한 동물 및 인간의 장내뿐만 아니라 발효식품 등에서도 분리되는 유산균으로 장내 환경에서의 생존 능력이 우수하고 다양한 생리활성 기능을 보유한 것으로 보고되어 왔다[6]. 특히, L. reuteri 균주는 다른 유산균과 달리 글리세롤(glycerol)을 이용하여 루테린(reuterin)이라는 저분자 항균물질을 생성할 수 있는 독특한 대사 특성이 있다[7]. 루테린은 3-hydroxypropionaldehyde 또는 β-hydroxypropionaldehyde로도 불리며 병원성 세균, 진균, 원생동물 등 다양한 미생물에 대해 우수한 항균 활성을 나타내는 것으로 알려져 있다[8]. 루테린은 미생물 내 티올기(-SH)와 상호작용함으로써 세포 기능을 저해하거나 구조적인 손상을 유도함으로써 세포 사멸을 유도하는 것으로 보고되었으며 기존의 박테리오신이나 유기산 기반 항균 물질에 비해 안정성과 지속성이 우수한 것으로 알려져 있어 산업적 응용 가치가 높은 물질로 평가되고 있다[9,10].
김치는 다양한 미생물이 공존하는 대표적인 발효식품으로 현재까지 수많은 유산균이 분리되어 기능성 소재로서의 가능성이 활발하게 연구되고 있다[11]. 특히 김치에서 분리된 유산균은 내산성, 내담즙성, 항균 활성 등에서 우수한 생리학적 특성을 나타내는 경우가 많아 프로바이오틱스로서의 활용 가치가 높게 평가되고 있다[12,13]. 그럼에도 불구하고 현재까지 김치로부터 분리한 L. reuteri 균주에 대해 루테린 생성능, 항균 활성, 안전성 및 장 부착능을 포함한 종합적인 프로바이오틱 특성을 분석한 연구는 제한적이며 특히 루테린 생성에 영향을 미치는 글리세롤의 농도 조건에 대한 연구도 미비한 실정이다.
따라서 본 연구에서는 김치로부터 분리한 L. reuteri SYU308 균주의 염기서열 분석을 통해 균주의 동정을 수행하고, 루테린 생성을 위한 글리세롤의 최적 농도 조건을 설정하며 루테린의 생성을 향상시키고자 하였다. 그리고 다양한 유해균을 대상으로 루테린 생성에 따른 항균 활성을 평가하고, L. reuteri SYU308 균주가 제품에 활용될 수 있도록 안전성을 평가하였다. 또한, L. reuteri SYU308 균주의 내산성 및 내담즙성을 평가하고, 인간 장 상피세포주인 Caco-2 세포를 대상으로 장 부착능을 조사하여 L. reuteri SYU308 균주의 프로바이오틱 특성을 체계적으로 분석하기 위해 수행되었다.
재료 및 방법
가정에서 담근 김치로부터 유산균을 분리하기 위해 김치 조각을 0.1% 펩톤수(peptone water)와 혼합한 뒤 LED Embossing Stomacher(BNF Korea, Korea)를 이용하여 1분간 균질화하였다. 멸균된 백금이를 이용하여 균질액으로부터 시료를 채취하고 Lactobacilli MRS agar(BD Difco, USA) 배지에 획선 도말한 뒤 37℃에서 48시간 동안 배양하여 개별 집락을 분리하였다. 분리된 균주들 중 항균 활성, 내산성 및 내담즙성이 우수한 균주 1종을 선발하여 동정하였다. 선발된 균주로부터 DNA를 추출한 후 forward primer(5'-GTG CCA GCM GCC GCG GTA A-3')와 reverse primer (5'-GGA CTA CHV GGG TWT CTA AT-3')를 사용하여 유전자를 증폭시켰다. 증폭된 유전자는 Sequencing Kit v3.0(PacBio, USA)을 이용하여 16S rDNA 염기서열을 분석하였으며 EZbioCloud, Swissprot, KEGG, SEED 데이터베이스에 등록된 염기서열과 비교하여 균주를 동정하였다.
동정된 L. reuteri SYU308 균주는 MRS 배지에서 3회 계대배양한 후 4,000×g에서 10분간 원심분리하여 상등액을 제거하였다. 이후 phosphate buffered saline(PBS; Sigma-Aldrich, USA)로 2회 세척한 뒤 최종 농도가 각각 100, 200, 300 및 400 mM가 되도록 글리세롤 수용액을 첨가하여 37℃에서 2시간 동안 배양하였다. L. reuteri SYU308 균주가 글리세롤을 대사시켜 생산된 루테린의 함량을 조사하기 위해 배양이 종료된 현탁액을 4,000×g에서 10분간 원심분리하여 상등액을 회수한 후 0.45μm syringe filter로 상등액을 여과하였으며 여과액은 루테린 함량 분석에 사용하였다. 루테린 정량을 위해 준비된 시료 0.5 mL에 10 mM Trp-HCl 용액 0.75 mL 및 37% HCl 1.5 mL를 혼합하고 40℃에서 20분간 반응시켰다. 반응이 종료된 시료는 microplate reader(SPARK, Switzerland)를 사용하여 560 nm에서 흡광도를 측정하였다. 루테린의 함량은 Reuterin (MedChem Express, USA)을 이용한 표준곡선을 기반으로 계산하였다.
L. reuteri SYU308 균주를 MRS broth 배지에 3회 계대배양하고 5% Sheep Blood Defibrinated(KisanBio, Korea)가 첨가된 혈액한천배지에 획선 도말한 후 37℃에서 48시간 동안 배양하였다. 배양 후 집락 주변에 흰색의 투명 환이 생성되면 베타-용혈 활성이 있는 것으로 판정하였다. 양성대조군으로는 베타-용혈을 유발하는 대표적인 균주인 S. aureus ATCC 25923 균주를 사용하였고 음성대조군은 안전성이 검증되어 다양한 프로바이오틱스 제품에 사용되고 있는 L. rhamnosus GG 균주를 사용하였다.
BSH 활성은 0.5% taurodeoxycholic acid(Sigma-Aldrich)가 첨가된 MRS agar 배지를 사용해 평가하였다. 실험에 사용된 L. reuteri SYU308 균주는 MRS broth로 계대 배양한 후 MRS-bile agar 배지에 획선 도말하였으며 37℃에서 48시간 동안 배양하였다. 배양 후 집락 주변에 흰색 환의 존재 여부를 확인하여 BSH 활성을 평가하였다. 대조군으로는 L. rhamnosus GG 균주를 사용하였다.
L. reuteri SYU308 균주의 항균 활성은 paper disc 확산법을 이용하여 평가하였다. 우선, L. reuteri SYU308 균주를 MRS broth에서 계대배양한 후 4,000×g에서 10분간 원심분리하여 상등액을 제거하였다. 이후 침전물에 300 mM 글리세롤 용액 10 mL를 첨가하고 2시간 동안 배양하여 루테린의 생성을 유도하였다. 같은 조건으로 다시 원심분리하여 상등액을 회수한 후 0.45μm syringe filter로 여과하여 항균 활성 측정을 위한 시료로 사용하였다. 항균 활성 평가는 유해균 19종을 각각 1%씩 접종한 적정 agar 배지를 준비한 후 여과액을 충분히 흡수시킨 paper disc를 해당 배지 위에 부착하여 37℃에서 24시간 동안 배양함으로써 수행하였다. 항균 활성은 paper disc 주변에서 유해균의 성장이 억제된 환의 크기를 측정하여 평가하였다.
내산성 평가를 위한 인공 위산은 다음과 같이 조제하였다. KCl 0.052 g, KH2PO4 0.016 g, NaHCO3 0.211 g, NaCl 0.277 g, MgCl2․6H2O 0.002 g, (NH4)2CO3 0.024 g을 증류수 100 mL에 용해한 후 121℃에서 15분간 멸균하였다. 멸균이 완료된 용액의 pH를 2.0으로 조정한 뒤 pepsin(Sigma-Aldrich)을 첨가하여 인공 위산을 조제하였다. 인공 위산 용액에 L. reuteri SYU308 균주를 1%(v/v) 비율로 접종한 후 37℃에서 3시간 동안 배양하였다. 배양 후 0.1% 펩톤수로 시료를 적절하게 희석한 뒤 MRS agar 배지에 접종하고 37℃에서 48시간 동안 배양하였다. 이후 L. reuteri SYU308 균주의 생존율을 확인하여 내산성을 평가하였다.
내답증성 평가를 위한 인공 담즙액은 다음과 같이 조제하였다. KCl 0.051 g, KH2PO4 0.014 g, NaHCO3 0.718 g, NaCl 0.225 g, MgCl2․6H2O 0.007 g을 증류수 100 mL에 용한한 후 121℃에서 15분간 멸균하였다. 멸균이 완료된 용액의 pH를 7.0으로 조정한 뒤 pancreatin(Sigma-Aldrich)과 bile extract porcine(Sigma-Aldrich)을 첨가하여 인공 담즙액을 조제하였다. 인공 담즙액에 L. reuteri SYU308 균주를 1%(v/v) 비율로 접종한 후 37℃에서 24시간 동안 배양하였다. 이후 내산성과 동일한 방법으로 L. reuteri SYU308 균주의 생존율을 확인하여 내담즙성을 평가하였다.
Caco-2 세포는 한국세포주은행(Korea)에서 분양받아 10% fetal bovine serum(GenDEPOT, USA)와 1% streptomycin/penicillin(Gibco, USA)가 첨가된 minimum essential medium(MEM; Welgene, Korea)를 사용하여 37℃, 5% CO2 조건에서 배양하였다. 24-well plate에 1×106 cells/mL의 Caco-2 세포를 분주한 뒤 세포 단층이 형성되도록 배양하였고, 각 well에 1×108 CFU/mL의 L. reuteri SYU308 균주를 분주한 뒤 37℃, 5% CO2 조건에서 2시간 동안 배양하였다. 배양 후 PBS로 3회 세척하여 Caco-2 세포에 부착되지 않은 L. reuteri SYU308 균주를 제거하였다. 그 다음 0.25% trypsin-EDTA(Gibco)를 처리하여 Caco-2 세포를 떼어낸 후 MRS agar 배지를 이용하여 37℃에서 48시간 동안 배양한 뒤 생균수를 측정하여 Caco-2 세포에 대한 부착 능력을 평가하였다.
결과 및 고찰
가정에서 담근 김치로부터 분리한 유산균 중 선행 연구를 통해 항균 활성, 내산성 및 내담즙성이 가장 우수한 1종을 선발하였으며 해당 균주의 염기서열 분석 및 동정 결과 L. reuteri 균주로 확인되었다(Fig. 1). 본 연구에서는 이 균주를 L. reuteri SYU308로 명명하였다.

L. reuteri SYU308 균주에 글리세롤을 첨가한 후 루테린의 생성량을 측정한 결과는 Fig. 2와 같다. 루테린 생성량은 글리세롤을 300 mM의 농도로 첨가할 때까지 농도 의존적으로 증가했으나 300 mM 이상의 농도에서는 유의적인 차이를 보이지 않았다. 루테린은 항균 효과가 매우 뛰어난 물질로 배양하는 과정에서 첨가된 글리세롤은 L. reuteri SYU308 균주에 의해 대사되어 루테린의 생성을 촉진시킬 수 있다[14]. 따라서 본 실험에서 루테린을 효과적으로 생성하기 위해 L. reuteri SYU308 균주에 첨가하는 글리세롤의 최적 농도는 300 mM으로 설정하였다.

베타-용혈은 적혈구가 완전히 용해되는 현상을 뜻하며 베타-용혈 활성이 있는 균주들은 sheep blood가 첨가된 혈액한천배지 내에서 흰색의 투명 환을 생성한다[15]. 특히, S. aureus ATCC 25923 균주는 베타-용혈 활성이 있는 대표적인 균주로 베타-용혈소(beta-hemolysin)를 분비하여 세포막을 파괴하고 적혈구를 용해시킨다고 알려져 있다[16]. L. reuteri SYU 308 균주의 베타-용혈 활성을 조사한 결과는 Fig. 3과 같으며 양성대조군인 S. aureus ATCC 25923 균주를 획선 도말한 혈액한천배지에서는 흰색의 투명 환이 생성되었다. 반면 L. reuteri SYU 308 및 L. rhamnosus GG 균주를 획선 도말한 혈액한천배지에서는 흰색의 투명 환이 생성되지 않아 베타-용혈 활성에 대한 안전성을 확인하였다. L. rhamnosus GG 균주는 기존의 연구를 통해 안전성이 검증되었고[17], Ryu and Chang[18]은 김치에서 분리된 Lactobacillus 균주들이 혈액한천배지 내에서 어떠한 환도 생성하지 않았다고 보고하였으며 이러한 내용들은 본 연구의 결과와 유사하였다.
L. reuteri SYU308의 BSH 활성을 시험한 결과 0.5% taurodeoxycholic acid가 첨가되지 않은 MRS agar 배지에서는 L. reuteri SYU308 및 L. rhamnosus GG 균주 모두 정상적으로 집락이 생성되었다(Fig. 4A). 반면, 0.5% taurodeoxycholic acid가 첨가된 MRS agar 배지에서는 L. reuteri SYU308 및 L. rhamnosus GG 균주 모두 집락이 생성되지 않아 BSH 활성에 대한 안전성을 확인하였다(Fig. 4B). 담즙산염은 지방을 유화시켜 지방 소화에 중요한 역할을 하는데 BSH는 담즙산염을 분해하여 지방이 체내로 소화 및 흡수되는 과정을 방해한다[19]. 또한 BSH에 의해 유화 기능이 상실된 담즙산염은 체내에서 독성을 가진 2차 대사산물을 생성할 수 있어 잠재적으로 위험성을 가질 수 있으므로 유산균의 BSH 활성을 확인하는 것은 안전성 측면에서 매우 중요하다[20].

L. reuteri SYU30 균주를 배양하는 과정에서 글리세롤을 첨가하여 루테린의 생성량을 증가시키고 상등액을 회수한 뒤 19종의 유해균을 대상으로 paper disc법을 이용하여 항균 활성을 평가하였다(Table 1). 그 결과 글리세롤 첨가로 인해 증가된 루테린 생성량이 특정 균주들을 대상으로 항균 활성을 증가시킬 수 있다는 사실을 확인하였다. 특히, L. rhamnosus GG 균주와 배양시 글리세롤을 첨가하지 않은 L. reuteri SYU308 균주는 A. viscosus ATCC 15988 및 F. necleatum ATCC 25586 균주를 대상으로 항균 활성이 확인되지 않았으나 배양시 글리세롤을 첨가한 L. reuteri SYU308 균주는 항균 활성을 나타내었다. 이러한 결과는 글리세롤 첨가로 인한 루테린 생성의 증가가 특정 유해균을 대상으로 항균 활성을 증가시킬 수 있다는 것을 보여주고, Ortiz-Rivera et al.[21]은 루테린은 저분자 화합물질로써 항균 활성이 매우 뛰어나며 유해균의 성장을 억제하는 능력이 매우 뛰어나다고 보고하였다.
본 연구에서는 L. reuteri SYU308 균주의 항균 활성을 비교하기 위해 L. rhamnosus GG 균주를 대조구로 사용하였다. L. rhamnosus GG 균주는 유기산 및 박테리오신(bacteriocin) 등을 생성하여 항균 능력이 뛰어나 유해균의 증식을 억제하고 장 건강 개선에 도움을 주는 프로바이오틱스로 잘 알려져 있다[22]. 그러나 S. typhimurium KCCM 11862, S. typhimurium KCCM 40253, S. sonnei ATCC 9290, S. epidermidis ATCC 12228 및 V. vulnificus ATCC 27562 균주 등 일부 유해균들에 대한 항균 활성은 L. rhamnosus GG 균주보다 글리세롤을 첨가한 L. reuteri SYU308 균주가 더 뛰어난 양상이 확인되었다. 이는 특정한 유해균들을 대상으로 유기산이나 박테리오신 등의 항균물질보다 루테린이 더 강력한 항균 활성을 나타낼 수 있다는 것을 암시한다. 또한 루테린은 단백질 분해 효소에 의해 쉽게 분해되지 않고 적정농도의 글리세롤을 첨가하는 간단한 방법으로 생성량을 증가시킬 수 있어 산업적인 활용 가능성을 인정받고 있다[23]. 그러나 루테린이 저분자의 티올기를 변형시키고 세포의 산화스트레스를 유발하여 항균 활성을 나타낼 수 있다고 보고한 연구 결과를 제외하면 아직 루테린의 항균 활성 기전은 규명되지 않았다[9]. 따라서 루테린을 효과적으로 활용하기 위해서는 루테린이 항균 활성을 나타내는 기전을 구체적으로 규명할 수 있는 후속 연구가 필요하다.
L. reuteri SYU30 균주의 생리학적 특성을 조사하기 위해 내산성 및 내담즙성을 평가하였으며 기존에 내산성 및 내담즙성이 뛰어나다고 알려져 프로바이오틱스 제품에 활용되고 있는 L. rhamnosus GG 및 L. acidophilus ATCC 4356 균주를 비교군으로 사용하였다. 유산균이 위장관을 통과하여 장에 도달한 뒤 기능성을 나타내기 위해서는 위산과 담즙산에 대한 내성이 필수적이다[3]. 내산성 및 내담즙성은 인공위액 및 인공담즙산 환경에서 L. reuteri SYU308 균주의 생존율을 측정하여 평가하였다. 그 결과 L. reuteri SYU308, L. rhamnosus GG 및 L. acidophilus ATCC 4356 균주는 인공위액에서 3시간 동안 처리한 후에도 각각 98.68%, 99.43% 및 98.95%의 생존율을 보이며 위산 환경에 의한 생존률 감소는 거의 관찰되지 않았다(Fig. 5A). 인공담즙산 환경에서도 L. reuteri SYU308, L. rhamnosus GG 및 L. acidophilus ATCC 4356 균주의 생존율은 각각 96.73%, 95.94% 및 95.90%로 담즙산에 대한 내성이 뛰어난 것으로 확인되었으며(Fig. 5B), 처리된 조건에서 각 균주의 생존율은 통계적으로 유의적 차이가 없었다. 또한, 이러한 결과는 김치에서 분리된 Lactobacillus 균주들이 pH 2.5 산성 조건과 1% 고농도 담즙산 환경에서도 95% 이상의 생존율을 나타냈다고 보고한 연구 결과와 유사한 양상을 보였다[24]. 유산균은 그 종류에 따라서 위산의 강한 산성이나 담즙산에 의해 세포막과 세포벽의 구조가 손상되어 생존률이 크게 감소할 수 있다[25,26]. 따라서 유산균이 산업적으로 활용되기 위해서는 산성 환경과 담즙산에 대한 내성이 필수적이다. 본 연구에서 인공위액 및 인공담즙산을 처리한 조건에서 L. reuteri SYU308 균주와 프로바이오틱스 제품에 사용되고 있는 L. rhamnosus GG 및 L. acidophilus ATCC 4356 균주의 생존율은 유사한 결과를 나타내었기 때문에 L. reuteri SYU308 균주의 내산성 및 내담즙성은 뛰어난 것으로 판단된다.

유산균의 기능성이 발현되기 위해서는 위장관을 통과한 후 장 상피세포에 부착하는 능력이 필수적이다[27]. 인간 장 상피세포 유래 Caco-2 세포를 대상으로 L. reuteri SYU308 균주의 부착 능력을 조사한 결과는 Fig. 6과 같다. L. reuteri SYU308, L. rhamnosus GG 및 L. acidophilus ATCC 4356 균주의 부착율은 각각 9.59%, 10.75% 및 2.79%로 나타났으며, L. acidophilus ATCC 4356 균주와 비교하여 L. reuteri SYU308 및 L. rhamnosus GG 균주의 부착율이 유의적으로 높게 확인되었다(p<0.05). 발효유 또는 김치로부터 분리된 Lactobacillus 균주의 Caco-2 세포에 대한 부착율이 약 2.10%–12.8%였다는 선행연구의 결과를 고려할 때[28,29], 본 연구에서 평가한 L. reuteri SYU308 균주의 부착 능력은 우수한 것으로 판단된다. 특히, L. reuteri SYU308 균주의 부착율은 상용 프로바이오틱스 균주인 L. rhamnosus GG와 유사한 수준으로 장내에서 일정 수준의 부착 및 정착 가능성을 가질 수 있음을 간접적으로 시사한다. 다만, 실제 장내 환경에서는 점액층, 숙주 면역반응 및 장내 미생물 간 상호작용이 복합적으로 작용하므로 본 연구 결과는 정착성을 완전히 설명하기에는 한계가 있으며 향후 in vivo 연구를 통해 추가적인 검증이 필요하다. 또한, 향후 연구에서는 Caco-2 세포 외에 다른 장 상피세포주를 대상으로도 부착 능력이 유사하게 나타나는지 확인할 필요가 있다.

결 론
본 연구에서는 김치로부터 분리한 L. reuteri SYU308 균주의 프로바이오틱스 특성을 평가하였다. 글리세롤 300 mM를 L. reuteri SYU308 균주에 처리하여 항균 활성이 뛰어난 루테린의 생성량을 증가시켰으며 일부 유해균에 대해서는 기존에 상업적으로 활용되고 있는 L. rhamnosus GG 균주보다 우수한 항균 활성을 보였다. 안전성 평가 결과 L. reuteri SYU308 균주 베타-용혈 및 BSH 활성이 나타나지 않아 체내에서의 안전성이 확인되었다. L. reuteri SYU308 균주는 인공 위산 및 인공 담즙산 환경에서 모두 높은 생존율을 보였으며 인간 장 상피세포주인 Caco-2 세포에 대한 부착증 또한 L. rhamnosus GG 균주와 유사한 수준으로 확인되었다. 이러한 결과들은 L. reuteri SYU308 균주가 항균 활성, 내산성, 내담즙성 및 장 부착능 등 다양한 프로바이오틱스 특성을 고루 갖추고 있으며 안전성 또한 확보된 균주임을 보여준다. 특히, 루테린의 생성에 기반한 항균 활성은 L. reuteri SYU308 균주의 산업적 활용 가능성을 높일 수 있는 요소로 판단된다. 향후 연구에서 루테린의 항균 기전과 L. reuteri SYU308 균주의 제품 적용 적성에 대한 연구를 수행한다면 L. reuteri SYU308 균주의 산업적 활용 범위를 확장할 수 있을 것으로 기대된다.